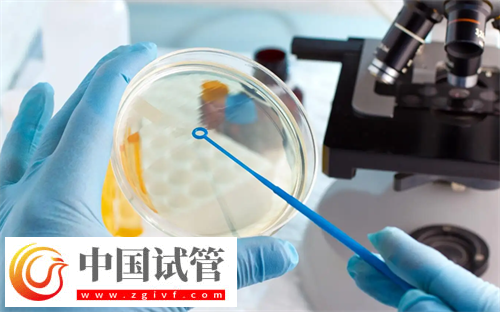
多囊患者試管選擇什么方案好？(圖1)

多囊患者試管選擇什么方案好?
對于多囊卵巢的患者來說,由于卵巢儲備功能較差,所以一般適合對卵巢刺激較小的促排方案,比如短方案、拮抗劑方案、微刺激方案等,這些方案會使用較少的促性腺激素,以刺激卵巢的卵泡發(fā)育,這對卵巢傷害較小的同時,還能有助于促排的成功,對此建議患者最好在醫(yī)生的指導(dǎo)下選擇合適的促排方案。
多囊患者試管選擇什么方案好
試管嬰兒治療不孕癥在臨床上很常見。比如多囊卵巢,這是一種排卵障礙性疾病,主要表現(xiàn)為卵巢增大,許多小囊充滿液體。其實卵巢里的卵子數(shù)量是比較多的,所以一般對于存在這種疾病的患者,可選擇以下幾種促排方案:
1、短方案
一般短方案在月經(jīng)周期的第2天開始使用促性腺激素進(jìn)行促排卵,適用于卵巢儲備功能較差的患者。所以對于多囊的患者,可在醫(yī)生指導(dǎo)下進(jìn)行短方案促排卵。
2、拮抗劑方案
做試管嬰兒多囊的患者,可以選擇拮抗方案,一般在促排卵過程中使用拮抗劑來抑制LH峰的方案,可促進(jìn)有效排卵的同時,并且還有效減輕卵巢過度刺激綜合征。
3、微刺激方案
對于存在多囊卵巢的患者,進(jìn)行微刺激促排卵方案也是個不錯的選擇,這樣可以通過使用較少的促性腺激素,以達(dá)到促進(jìn)卵泡的發(fā)育和成熟的作用,通常是比較適用于卵巢反應(yīng)不良或高齡患者的。
選擇微刺激方案的成功率多少
微刺激方案是指在僅使用極少量的促排卵藥物來達(dá)到幫助患者促排卵作用的方案,是試管治療中較為常用的一種方案。因為試管患者當(dāng)中,有不少患者是高齡、卵巢儲備功能嚴(yán)重衰退、卵巢無法受藥物刺激的情況,所以這時候微刺激方案就會發(fā)揮出它的作用了,微刺激方案對卵巢的用藥量少,對卵巢的刺激作用小,所以發(fā)生卵巢過激的幾率非常之低,也能夠?qū)颊叩穆殉财鸬奖苊獯碳Φ淖饔谩?/p>
微刺激的成功率維持在30%左右,但隨著年齡的增加成功率逐漸降低,>40歲成功率<10%。雖然微刺激成功率低,當(dāng)每個周期的成功率維持不變,特別是前4個周期成功率較高。治療4個周期累計成功率可達(dá)45%左右。





